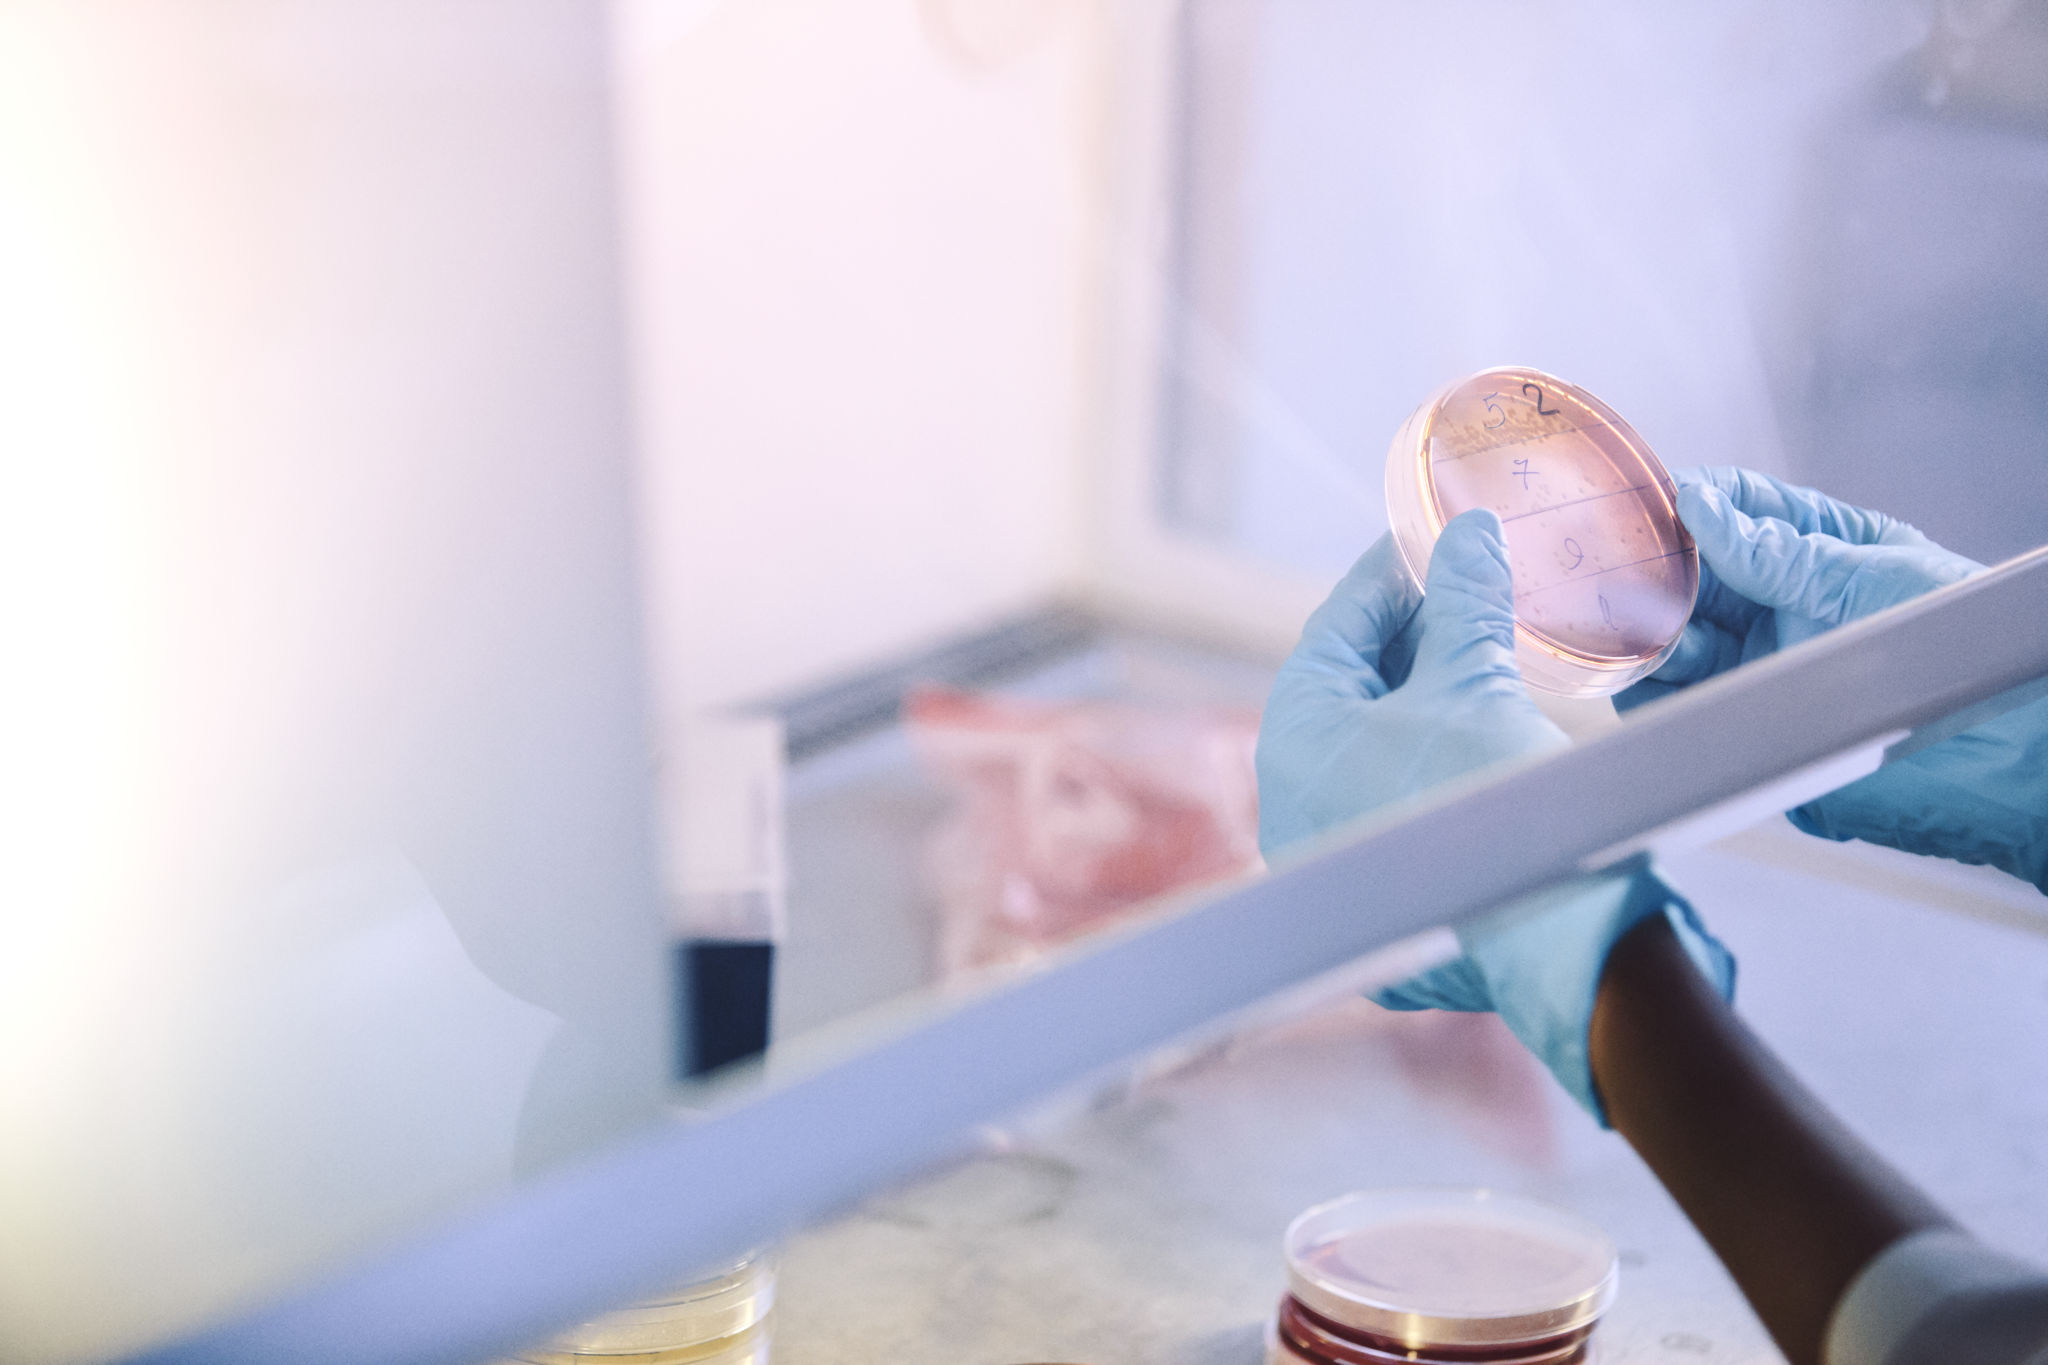
Petriskålar i dragskåp.

News

The PhD Prize of the ÅAU alumni association to Krishna Kanhaiya
Mr Krishna Kanhaiya, M.Sc., and PhD student at Åbo Akademi University has been awarded Akademikerpriset 2018.
Akademikerpriset is the PhD prize of the Åbo Akademi alumni association. It is awarded once every two years to a young promising PhD student. The prize amounting to 5 000 euros was presented at the Brahebalen alumni banquet on 27 January, 2018.
Krishna Kanhaiya was born in India in 1987. After completing his Bachelor’s degree in computer science and his Master’s degree in bioinformatics in his native country, he was admitted for PhD studies in computer science at Åbo Akademi University in 2015.
Krishna Kanhaiya’s PhD project is at the intersection between computer science, bioinformatics, and biomedicine. His focus is on network algorithmics to studies of complex diseases, especially cancer, with the aim of finding new efficient combinatorial therapeutic strategies.
Krishna Kanhaiya is decribed as an outstanding PhD student whose work has been received with high praise in the international community. He is distinguished by his versatile scientific background, with strong skills in bioinformatics, data analytics, and programming as well as strong work ethics and commitment to achieving his goals. Krishna Kanhaiya will defind his doctoral thesis in the spring of 2019. Supervisor is Ion Petre, Professor of Computer Science at Åbo Akademi University.

